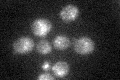
YDL010W
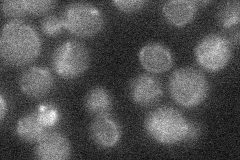
YDL010W
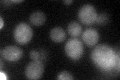
YDL010W
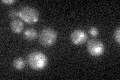
YDL010W

View description
Cis-golgi localized monothiol glutaredoxin that binds an iron-sulfur cluster; more similar in activity to dithiol than other monothiol glutaredoxins; involved in the oxidative stress response; functional overlap with GRX7
Localization:
Intensity:
Fold change:
Significance:
-
C’ GFP library in SD
vacuole23.82 -
N' NOP1pr-GFP in SD

vacuole52.3593 -
N' TEF2pr-mCherry in SD

vacuole23.0669 -
N' NATIVEpr-GFP in SD
below threshold18.4587 -
N' TEF2pr-VC and Cyto-VN in SD

#N/A0 -
C’ GFP library in SD+DTT
vacuole24.341.02No -
C’ GFP library in SD+H2O2
vacuole17.210.72Yes -
C’ GFP library in Starvation Media

vacuole32.451.36Yes -
C’ GFP library on the background of Pup2-DaMP

vacuole -
C’ GFP library on the background of CCT mutant

vacuole20.67840.867919No
